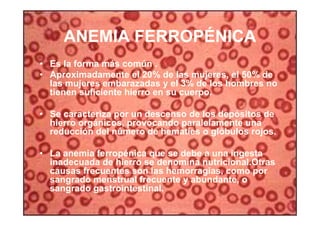
39
ANEMIA FERROPÉNICA
• Es la forma más común .
• Aproximadamente el 20% de las mujeres, el 50% de
las mujeres embarazadas y el 3% de los hombres no
tienen suficiente hierro en su cuerpo.
• Se caracteriza por un descenso de los depósitos de
hierro orgánicos, provocando paralelamente una
reducción del número de hematíes o glóbulos rojos.
• La anemia ferropénica que se debe a una ingesta
inadecuada de hierro se denomina nutricional.Otras
causas frecuentes son las hemorragias, como por
sangrado menstrual frecuente y abundante, o
sangrado gastrointestinal.

El documento resume las principales características del corazón y el sistema circulatorio. Explica que el corazón está formado por tres capas y cuatro cavidades, y bombea sangre de forma rítmica a través de arterias, venas y capilares sanguíneos. La sangre recibe oxígeno en los pulmones y nutre los tejidos a través de una compleja red vascular antes de regresar al corazón.